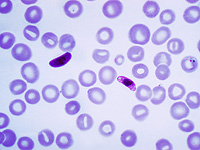
Израильские ученые разобрали защитную систему малярийного плазмодия и показали, как ее разрушить

ВСЕ НОВОСТИ
390-й день войны: ЦАХАЛ действует в Газе, атаки из Ливана. Хронология
Самолеты ЦАХАЛа нанесли удар по боевикам ХАМАСа и "Исламского джихада", использовавшим "гуманитарную зону" в Хан-Юнисе для осуществления атак. ЦАХАЛ продолжает атаковать объекты "Хизбаллы" в Ливане. Военные действуют в Иудее и Самарии.
adv_09 rimma_dw_d
adv_10 rimma_dw_m
adv_11 ca_instrip_direct
Суд Парижа разрешил израильским компаниям участвовать в выставке вооружений Euronaval
Суд Парижа по международным коммерческим спорам признал незаконным запрет на участие израильских компаний в выставке вооружений Euronaval. Инициатором запрета было правительство Франции, его поддержал президент Эммануэль Макрон.
adv_12 ca_instrip_direct
adv_12 ca_instrip_direct
adv_12 ca_instrip_direct
adv_12 ca_instrip_direct
adv_12 ca_instrip_direct
Наводнения в Испании, десятки погибших. Фоторепортаж
По меньшей мере 51 человек погиб в Испании в результате наводнения, вызванного проливными дождями. Наиболее пострадали регионы Валенсия и Андалузия на востоке и юге страны. Точное число жертв стихии пока не установлено. Поисково-спасательные работы, к которым привлечены и сотни военнослужащих продолжаются, отдельные районы остаются изолированными.
adv_12 ca_instrip_direct
adv_12 ca_instrip_direct
adv_12 ca_instrip_direct
adv_12 ca_instrip_direct
ВСЕ НОВОСТИ ::
29 Октября 2024 г.